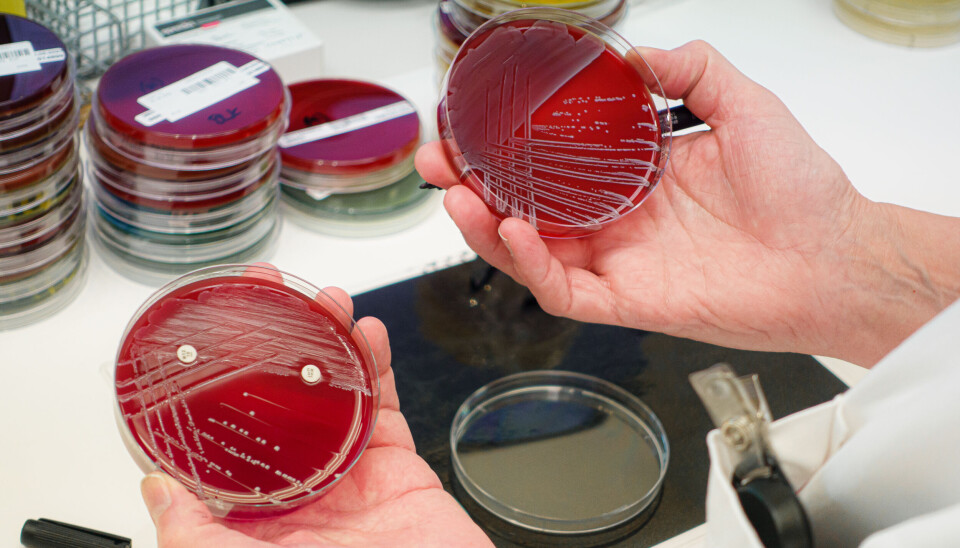

Hurtigdiagnostikk er nødvendig for å vinne kampen mot antibiotikaresistens
Uten rask diagnostikk blir antibiotikabehandlingen i de første timene og dagene kvalifisert gjetting. Vi må få opp farten, ellers vinner bakteriene krigen.

Se for deg en situasjon der en pasient har en infeksjon, men ingen av de antibakterielle midlene pasienten har fått gir behandlingseffekt. Pasienten blir dårligere og står i akutt fare for å utvikle blodforgiftning.
Hva om det viser seg at legen har gitt antibiotika mot en annen bakterie enn den som herjer i kroppen til pasienten, fordi prøvesvarene fra laboratoriet lar vente på seg? Dette er et helt realistisk scenario for helsepersonell som skal hjelpe pasienter med alvorlige infeksjoner.
Men det finnes løsninger, og vi har testet en av dem på Haukeland - med gode resultater. Denne løsningen vil bli et nyttig verktøy for helsevesenet når Norges nye nasjonale én-helse strategi mot antimikrobiell resistens 2024-2033 skal settes ut i live i tiden som kommer.
Diagnose på to timer
Rask diagnostikk av smittsom sykdom er krevende å utvikle, men ikke umulig. Mye har skjedd på dette området i løpet av de siste 25 årene. Der vi før brukte dager på å stille riktig diagnose, kan vi nå få presise svar i løpet av to timer.
I våre forskningsprosjekt, som er finansiert av Norges forskningsråd, Trond Mohn forskningsstiftelse, Universitetet i Bergen og Haukeland universitetssykehus, har vi testet pasienter som kom inn til akuttmottaket med mistanke om lungebetennelse. Vi tok prøver fra luftveiene til pasientene, så testet vi prøvematerialet med en ny hurtigdiagnostikk og fikk ut et presist svar etter to timer.
Hadde vi måttet vente på svaret fra vanlige dyrkingsprøver på laboratoriet ville svaret kommet dagen etter. Eller dagen etter det igjen.
Rask og riktig antibiotikabruk
Rask diagnostikk gjør at legen kan få tilgang til raske relevante resultater. Dermed blir det også mulig å starte målrettet antibiotikabehandling mye tidligere. Og - det blir mulig å unngå antibiotikabehandling dersom pasientens sykdom skyldes et virus.

Hvis vi får til rask prøvetransport fra fastleger og sykehjemsleger til mikrobiologisk laboratorium, og rask elektronisk formidling av prøvesvar tilbake til den som rekvirerer, kan også leger og pasienter i allmennhelsetjenesten få korrekte prøvesvar i løpet av et døgn. Det gjør det mulig å starte rask behandling med riktig antibiotikum, istedenfor å skyte fra hoften mens vi venter på svaret fra laboratoriet.
Å få ned antibiotikabruken er viktig, fordi det er en klar sammenheng mellom mengden antibiotika vi bruker og utviklingen av resistente mikrober. Jo mer antibiotika, jo mer antibiotikaresistens.
Ved å utvikle rask diagnostikk vil vi dermed oppnå to gevinster – antibiotikabruken i samfunnet blir lavere, og pasienten behandles riktig fra starten av.

Nødvendig investering
Det er kostnadskrevende å legge til rette for hurtigdiagnostikk gjennom hele døgnet og hele uken, men hvis vi skal kunne begrense utviklingen av antibiotikaresistens er det et nødvendig tiltak.
Derfor utfordrer vi både departementer og helseforetak til å tenke hurtigdiagnostikk, når de nå skal lage egne handlingsplaner for å følge opp den nye nasjonale strategien mot antimikrobiell resistens.
Særlig siden det nesten ikke utvikles nye antibiotika vil hurtig og presis diagnostikk være en viktig strategi i kampen mot resistente bakterier.
Ingen oppgitte interessekonflikter